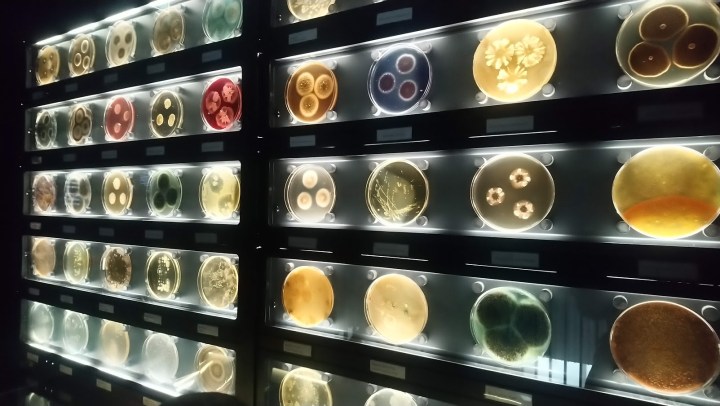
DSC_0268

Last June I went to Amsterdam, tourist hotspot of the Netherlands, for a weekend…except it wasn’t even a whole weekend. It was more like a day and a little bit. While it seemed like a fantastic idea when I had booked it, it actually turned out to be an annoyingly short amount of time. I guess what I’m trying to say is…if you’re going to Amsterdam – or anywhere really – it’s probably best to give yourself a couple of days, at least.

As is common in my life, I travelled alone so this is Amsterdam from that perspective. As with all adventures, the experience of doing it alone and doing it with other people are totally different experiences.
So I arrived in Amsterdam late on Friday night (it was so late that it was almost Saturday morning!) and I just wanted to mention this so that I could tell you all how wonderful my Friday night hotel – the Corendon – was. It was by far the nicest hotel I’ve stayed in during any of my travels (which isn’t that hard to be honest, but trust me it was niiiiice!). I probably could have just stayed in this hotel during my whole trip – in addition to having really nice rooms (my standards are pretty low in accommodation, let’s face it) it also had a pool and gym, a shopping centre, a cinema and a spa (if memory serves me correctly). If you’re looking for somewhere to stay near Schiphol Airport, I thoroughly recommend the Corendon.

So on the Saturday I got up as early as my body would allow me (I was already exhausted, never a great idea when you’re adventuring!) checked out of the nice hotel and hopped on the shuttlebus into Amsterdam. I had opted for the iAmsterdam Card (it’s no secret that I can’t resist a wee travel pass!) so my first mission was to try and collect that. I then tried to play a sightseeing quiz which I had bought and downloaded, but unfortunately I couldn’t get it to work so that was a disappointment – a waste of £3 and about half an hour (which maybe doesn’t seem like a lot of time, but when you only have one day every minute counts!).
So my first actual activity was hopping on a boat for a canal cruise! Since the canals are such a major attraction in Amsterdam this seemed like a good place to start and it’s always nice to get a different view on the world.
After my cruise I enjoyed a short walk along the canal to collect my thoughts, and popped into the Hard Rock Cafe for some souvenirs while I was in the vicinity.

I then made the decision to make my way to the Rijksmuseum, and upon arrival discovered a little cafe in Rijks Garden selling an Amsterdam staple – stroopwafels. This delicious sweet treat was the perfect pick me up before I headed inside…

Inside the Rijksmuseum I took my time perusing all of the various exhibits and artworks. It will come as no surprise that the library was my absolute favourite! The modern artworks on the final floor are …particularly interesting. Definitely don’t skip them if you’re visiting.
After the Rijks, I decided to book a slot for the Van Gogh Museum. Unfortunately you can’t just turn up at this one, due to how incredibly popular it is, so you have to book a ticket in advance for a specific time slot and then stick to your time. This staggers entry, but once your inside you can browse at your leisure for as long as you want.

By the time I had tried to absorb all of the artistic talents and creative vibes, the exhaustion was well and truly kicking in. I could feel myself starting to get irritable, so I joined everyone else who was sitting in the park – where there was an urban sports festival going on – and just chilled for a while. I never normally allow myself to chill but it definitely really helped – I wasn’t quite ready to call it quits on my day of exploring quite yet!
I was able to fit in one last thing before going to find my Saturday night accommodation, and that was the Diamond Museum which was situated super close by to the Van Gogh Museum. There was actually quite a few interesting looking small museums in this area, but this was the only one which was both included in my travel card and open.
I was actually the only person in during my visit, but when I was perusing the gift shop (which even sold Walkers Shortbread, which blew my Scottish mind) a few people came in and left when they were told the price of the tickets. If you have an iAmsterdam Card and are in the area, however, it’s definitely worth popping in to ogle at all the pretty shiny things.

I then made my way to my accommodation, which turned out to be an adventure in itself. Not because it was poorly located – I had no problem getting from the centre to my bed and breakfast – but the owner had to come and rescue me when I couldn’t find the right house. I had a small single room and a shared bathroom, but there was also an roof patio (where I ate breakfast with the cat Layla) and a courtyard which the owner made very clear was “smoke friendly” (no, I didn’t). This place actually perfect for my needs (apart from almost having a breakdown when I couldn’t find it) and I would definitely recommend it or consider staying there if I visit again! Once I checked in that was me for the night – I was shattered!

After breakfast with Layla I enjoyed a short walk along the canal beside my accommodation and took a mini adventure onto one of the nearby funky bridges.
I then took the bus to Amsterdam Zoo which was insanely busy! There was lots to see, but I definitely struggled a bit with the crowds. I ended up making friends with one of the zoo staff after she told me to keep my children under control…and I had to tell her that they weren’t my children (laugh emoji). She rolled her eyes and complained about people not following the rules and we both had a laugh.
I still had some time to play with after leaving the zoo (I’m used to zoos taking up more time than I budgeted for, this one was the opposite possibly due to the crowds!) before heading to catch my flight so I popped next door to Micropia.
Micropia is a science museum which helps you to get closer to germs, bacteria, viruses, etc than you ever thought you could want to be. This museum, although an impulse decision, was definitely a lot of fun and the interactive stamps which you collect as you go round and then bring to life at the end was definitely lots of fun for all ages!

Then it was time to head to the airport….and my adventure was over!
While you’re here why not check out my itinerary reviews for 48 Hours In Oslo or 48 Hours In Copenhagen?
